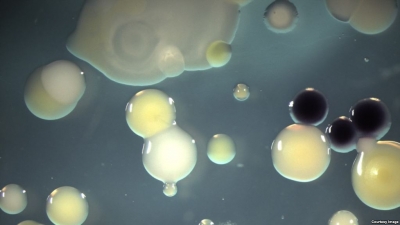

Lajmet e fundit

Ç’ndodh me portin e Durrësit/ Media gjermane: Kompania fiktive dhe lidhjet e errëta
“Përshkallëzohet drama në portin e Durrësit. Detaje të reja mbi kompaninë fiktive kroate dhe lidhje të mundshme kriminale”. Me këtë titull e përditshmja gjermane “Focus Online” i ka kushtuar vëmendje...

'Rinia iku, kryehajduti godet pensionistët', Hajderasi: Ku e gjeni buxhetin për kupolën tuaj kriminale?
Nga Rruga e Shpresës, në tubimin qytetar, anëtarja e FRPD, Alda Hajderasi tha se Edi Rama, pasi largoi rininë, ka filluar të godasë ata që kanë ngelur, pensionistët. SPAK pse nuk...

'Takimi me shqiptarët në Londër', Lela: Atdheu që keni lënë, nuk është ai që Edi Rama dhe Taulant Balla ju paraqesin
Shqiptarët që jetojnë në Britaninë e Madhe i janë përgjigjur masivisht ftesës së bërë nga kryetari i PD-së, Sali Berisha për një takim në Londër. Drejtori i komunikimit në PD, Alfred...